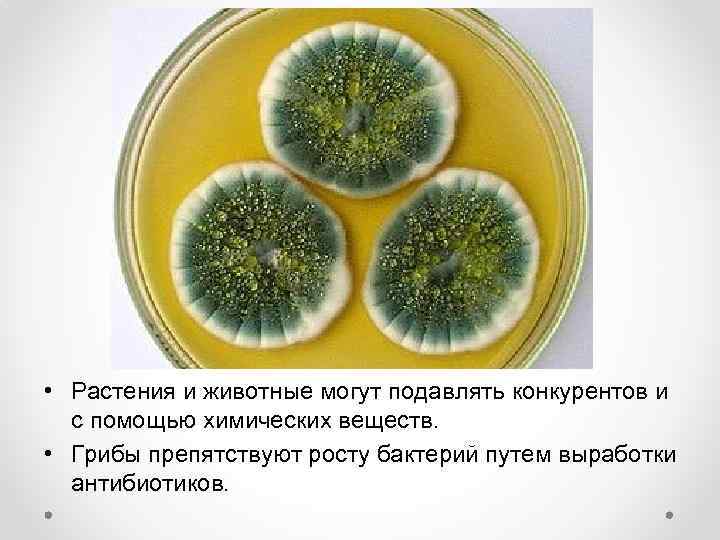
• Растения и животные могут подавлять конкурентов и с помощью химических веществ. •

Антибиотические отношения 3 Конкуренция.pptx
- Количество слайдов: 14

Антибиотические отношения Часть – 3. Конкуренция

• Антибиоз — форма взаимоотношений, при которой обе взаимодействующие популяции или одна из них испытывают отрицательное влияние. Антибиотические отношения • Хищничество • Паразитизм • Конкуренция

Конкуренция • Этот тип взаимоотношений возникает, если у двух близких видов наблюдаются сходные потребности. • Если такие виды обитают на одной территории, то каждый из них находится в невыгодном положении: уменьшаются возможности овладения пищевыми ресурсами, местами для размножения и т. д.

• Формы конкурентного взаимодействия могут быть самыми разными — от прямой физической борьбы до мирного совместного существования. Но, рано или поздно один конкурент вытеснит другого. • Ч. Дарвин считал конкуренцию одной из важнейших составных частей борьбы за существование, играющей большую роль в эволюции видов. Ч. Дарвин

• Как бы ни были сходны потребности видов, все же они отличаются друг от друга устойчивостью к факторам среды — температуре, влажности и т. п. Скорость размножения видов уже по этим причинам будет неодинакова. • С каждым поколением все больше пищевых ресурсов будет захватываться особями конкурентоспособного вида, при этом другой вид неизбежно исчезнет.

• Часто конкуренты активно действуют друг на друга. • У растений это может быть перехват минеральных солей и влаги корневой системой, солнечного света — листьями.

• В смешанных посевах трав преимущество получают виды с более длинными листовыми черешками. • В смешанных посадках деревьев быстрорастущие экземпляры будут затенять и угнетать медленно растущие деревья.
• Растения и животные могут подавлять конкурентов и с помощью химических веществ. • Грибы препятствуют росту бактерий путем выработки антибиотиков.

• У животных встречаются случаи прямого нападения представителей одного вида на другой. В результате более слабый конкурент погибает или ищет свободную территорию.

• Одним из путей регуляции плотности населения данного вида в биогеоценозе служит маркирование занимаемой особью или семьей территории. Оставляемый животным запах служит сигналом, предупреждающим, что территория занята.

• В результате конкуренции в биогеоценозе совместно уживаются только те виды, которые смогли разойтись в своих требованиях к условиям жизни. Например, копытные африканских саванн по-разному используют пастбищный корм. Зебры обрывают верхушки трав;

• антилопы кормятся тем, что оставляют им зебры, выбирая при этом определенные виды растений;

• газели выщипывают самые низкие травы,

• а антилопы топи едят сухие стебли, оставшиеся после других травоядных.
Антибиотические отношения 3 Конкуренция.pptx